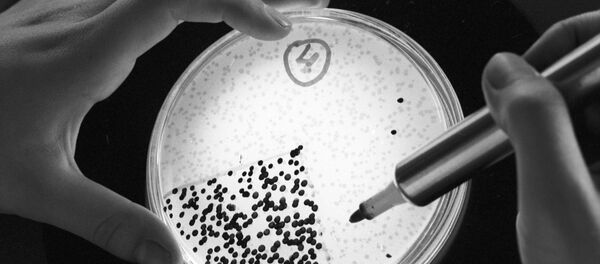
Бактериялар таҳлили - Sputnik Ўзбекистон

ТОШКЕНТ, 2 ноя – Sputnik. Фуқаро ҳуқуқларини ривожлантириш мавзусида 30 октябрь куни бўлиб ўтган кенгашда Владимир Путин “Кимдир бутун мамлакат бўйлаб биологик материаларни йиғмоқда. Россияда яшаётган турли миллат ва элатлар бўйича ҳам. Шу ўринда савол туғилади, хўш бу нима учун қилинаяпти?”, — деб ҳукумат аъзоларига мурожаат қилди, РИА Новости хабарига асосан.
Аслида, ушбу шов-шув АҚШ Ҳаво-ҳарбий кучлари томонидан 2017 йилнинг 18 июлида Federal Business Opportunity сайтида чоп этган эълонидан бошланди. Унда айтилишига кўра, АҚШ Ҳаво кучлари қўмондонлиги россиялик кишиларнинг Рибонуклеин кислотаси (РНК) ва инсон суяги бўғимининг синовиал кислота ишлаб чиқарувчи қатлами намуналари жамлаётганини хабар қилган.
Хабарда айтилишига кўра, юқоридаги биологик материаллар фақат Россияда яшаётган европеоид ирқига мансуб шахсларга тегишли бўлиши кераклигини таъкидланган. Украиналикларнинг биологик материаллари қабул қилинмаслиги ҳам алоҳида айтиб ўтилган.
РНК — Инсон танасидаги энг асосий учта макромолекулалардан бири. Қолган иккитаси ДНК ва оқсил молекулаларидир. Турли миллат, турли ирқ вакилларида улар турли турли кўринишда бўлади. Агар айнан бир хил турдаги ДНК, РНК ёки оқсил молекуласига зарар еткизувчи вирус етиштирилса, унинг ёрдамида фақат маълум бир миллат ёки ирқ вакилларига таъсир қилувчи биологик қурол ишлаб чиқариш мумкин.
Пентагон – бу хорижий фуқаролар соғлиги ҳақида қайғурувчи, тиббиёт илмий-текшириш иститути эмас. Пентагон бу ҳарбий мақсадларга эриши ташкилоти. Бугунги кунда МДҲ ҳудудида АҚШ назорати остида бўлган ўнлаб биологик лабораториялар ишламоқда. Улар собиқ Иттифоқнинг ҳар бир миллати учун ўзига мос вируслар тўпламини яратмоқда. Ахир ядро уруши бошланса америкаликларнинг ўзи ҳам зарар кўриши мумкин, биологик уруш эса ҳеч кимга кўринмайди из ҳам қолдирмайди.
Кўринмас учинчи жаҳон уруши
Биология ва генетика фанларининг бугунги тараққиёти, одамларни ирқи, терисининг ранги ёки яна бошқа белгиларига кўра танлаб йўқ қилишга қодир бўлган бактереологик ёки био-генетик қурол яратишга қодир. Балким шунинг учун америкаликлар МДҲ ҳудудида юқори ҳимояланган муҳандислик-биологик лабораториялар сонини оширмоқда. Охирги етти йил ичида бутун дунё бўйлаб қурилган АҚШ био-муҳандислик лабораториялар сони 20 тадан 400 тага етди.
Пентагон ана шундай объектларни Озарбайжон, Арманистон, Грузия, Қозоғистон, Молдавия, Ўзбекистон ва Украина ҳудудларида барпо этишга улгурган. АҚШ расмий хабарига кўра улар – биологик хавфларнпи олдини олиш учун. Аслида эса, ушбу лабораториялар ўзлари жойлашган мамлакатлар боши узра кўтарилган қиличга ўхшайди.
Охирги йиллар давомида ана шундай объектларда юзлаб бахтсиз ҳодисалар юз бергани қайд этилган бўлсада, АҚШ маъмурияти бактереологик ва токсин қуроллар ишлаб чиқиш, уларнинг заҳираларини тайёрлаш ҳақидаги Халқаро конвенция нормаларини инкор қилиб келмоқда.
Шу ўринда этник йўналтирилган вируслар Америкада тарихида муҳим рол ўйнаганини қайд этиш лозим. Шимолий Америка қитъасини эгаллаб олишда ҳиндуларнинг энг кўп ўлимига сабаб бўлган нарса, бу жанглар эмас – европаликлар ўзлари билан олиб келган касалликлар бўлган экан. Алоҳида материкда яшаган ҳиндуларнинг европада кенг тарқалган вабо, сил ва бошқа касалликларга қарши иммунитети бўлмагани туфайли улар миллионлаб қирилиб кетган. Шу тариқа Америкада 15 млн ҳиндудан 20 аср бошига келиб 300 минг киши қолган экан.
Ген-муҳандислигининг бугунги кундаги ривожланиш даражасини ҳисобга олганда, дунёнинг юзлаб нуқталарида жойлашган бундай лабобраториялар ғаразли ниятда бўлган душманга катта имкониятлар бериши мумкин.
Охирги вақтларда Россиянинг Жанубида қишлоқ хўжалик эпидемиялари сони ошиб бормоқда. Мутахассислар фикрига кўра, шимолий ярим шарда Африка вабоси тарқалишига фақат бир сабаб бўлиши мумкин – бу ўша вируснинг лаборатория шароитида модификация қилинишидир.
Ямал оролида 2016 йилда бирдан тарқалган куйдирги (Сибиркая язва) вируси ҳам ўта шубҳали ҳолатдир. Ўтган 75 йил давомида бунақаси кузатилмаган эди. Бир зумнинг ўзида 24 нафар маҳаллий аҳолидан куйдирги вируси топилди. 2500 бош зарарланган кийикларни йўқ қилиб ташлашга тўғри келди. Мутахассислар фикрига кўра, бу диверсия бўлиши эҳтимолдан холи эмас.
АҚШ биологик марказлари ходимлари ўзлари бажараётган ишларнинг охирги мақсади нима эканлигидан хабари бўлмаслиги ҳам мумкин. Пентагон микробиологлари олиб бораётган ишниниг стратегик муҳим аҳамиятга эга эканлиги ушбу мақсадда харажат қилинган маблағлар миқдоридан ҳам билиб олиш мумкин: Украинада 175 млн, Грузияда – 150 млн, Қозоғистонда – 130 млн. доллар. Ваҳоланки, охирги йилларда энг хавфли вируслар ҳужумлари Африка ва Жанубий Осиё қитъаларида бўлиб ўтмоқда. Украина, Грузия ёки Қозоғистонда бундай эпидемиялар кузатилгани йўқ.
Жавоб чоралари
Россия ўз ҳудудида эпидемиологик ва вирусологик хавфсизлик чораларини кўрган ва маълум назорат чораларини ҳам сақлаб қолган. Афсуски, МДҲнинг Озарбайжон, Грузия, Қозоғистон ва Украина каби баъзи мамлакатлари, АҚШ ёрдами эвазига, нафақат ўз ҳудудларини Пентагоннинг биологик экспериментлари учун очиб беришган, балким америкаликларга собиқ СССР даврида ишлаб чиқилган биологик қурол намуналарини: зарарли касаллик қўзғатувчи ва жанговор вирус штаммларини ҳам бериб юборишган. Бундай йўқотишларни ўрнини босиш жуда мушкул.
Эслатиб ўтамиз, собиқ Иттифоқ даврида вабо, куйдирги, қорачечак, Ласса ва Эбола вируслари асосида, улардан кўра бир неча борбар хавфли бўлган, ҳар қандай ҳимоядан ўтиш қобилиятига эга бўлган “жанговар вируслар” ишлаб чиқарилган эди.
Ҳар қандай биологик қурол шубҳасиз бутун дунёнинг эртанги кунига хавф солади. Назоратсиз ўтказилаётган тажрибалар бутун мамлакат ёки халқларнинг қирилиб кетишига олиб келиши мумкин. Шу сабабли дунёнинг аксарият мамлакатлари Биологик қурол тарқалишини олдини олишга қаратилган 1925 йилги Женева конвенцияси, 1972 йилги халқаро конвенцияларга аъзо бўлган ва биологик қурол тарқалмаслиги тарафдори. АҚШ бўлса, якка тартибда 2001 йилда ушбу конвенциялардан чиқиб кетган.
Айтиш жоизки, бугунги кунда биологик қуролларнинг турли кўринишлари ишлаб чиқарилмоқда. Биологик қурол инсон генетикасини, психиологиясини, иммунитетини ёки насл яратиш қобилиятига қарши қаратилган бўлиб, у бутун бошли миллатларни бирор дона ўқсиз қириб юбориши мумкин.
Лотин Америкасида 2015 йилда 3-4 млн кишига юққан Зика лихорадкасини эсга олинг. Зика вируси ҳомиладор аёлларнинг ҳомиласига зарар еткизиш хусусиятига эга эди. У боланинг бош миясида микроцефалия касалига олиб келар ва натижада гўдак нобуд бўлар экан. Зика вирусининг табиий манбааси қаерда эканлиги ҳали ҳам аниқланмаган. Буни шунчаки тасодиф дейиш мумкинми?
Ёки 2016 йилда Жанубий Кореяда тарқалган Эбола лихорадкасини эсласак. Ўшанда ОАВлар Эбола вируси АҚШ биологик лабораторияларидаги бахтсиз ҳодиса оқибатида одамлар орасида тарқалиб кетган деб ёзган эди.
Ундан ташқари биологик қурол қишлоқ хўжалигига ва мамлакат иқтисодига ҳам улкан зарар еткизиши мумкин. “Қуш гриппи” ёки “Чўчқалар гриппи” эпидемиялари айрим мамлакатлар (масалан Хитой) иқтисодига миллионлаб доллалик зарар еткизгани ҳаммага маълум.
Россия ўз халқи ва миллатини ҳимоя қилиш мақсадида, биологик қурол хавфи ҳақида нафақат бошқаларни огоҳлантириш, балким ҳимоя чизиғи яратиш йўлидан бормоқда. Шу сабабли бошқа МДҲ мамлакатлари ҳам ушбу хавфлардан огоҳ бўлиб “соғломлашиш” йўлига ўтса мақсадга мувофиқ бўлар эди.